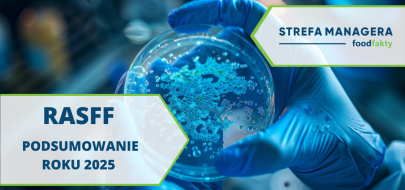

EFSA publikuje nowy katalog dokumentów wytycznych. Ma usprawnić dostęp i wykorzystanie wiedzy naukowej
Europejski Urząd ds. Bezpieczeństwa Żywności (EFSA) poinformował o wdrożeniu nowego katalogu dokumentów wytycznych, którego celem jest poprawa dostępu do zasobów oraz ich praktycznego wykorzystania przez interesariuszy sektora żywnościowego.
Nowe rozwiązanie stanowi element szerszej modernizacji sposobu opracowywania, opisywania i udostępniania wytycznych EFSA. Jak podkreśla Urząd, zmiany mają ułatwić ich wyszukiwanie, zrozumienie i stosowanie zarówno przez naukowców, jak i podmioty składające wnioski czy instytucje współpracujące.
Jeden punkt dostępu do wytycznych
Centralnym elementem zmian jest uruchomienie Katalogu dokumentów wytycznych EFSA, który umożliwia przeszukiwanie i dostęp do wszystkich aktualnych, wycofywanych oraz archiwalnych dokumentów w jednym miejscu.
Dodatkowo wprowadzono także Bibliotekę dokumentów UE dot. wytycznych w zakresie bezpieczeństwa żywności – bibliotekę gromadzącą dokumenty opracowane przez krajowe instytucje i organy oceny ryzyka w państwach członkowskich UE.
Nowa klasyfikacja i większa przejrzystość
EFSA zaktualizowała również definicje dokumentów wytycznych, wprowadzając podział na pięć kategorii. Klasyfikacja uwzględnia m.in. cel dokumentu, jego zakres zastosowania, stopień obowiązywania oraz podmiot odpowiedzialny za jego przyjęcie.
Dokumenty te obejmują m.in.:
- wytyczne przekrojowe (metodologiczne),
- wytyczne sektorowe,
- standardy danych i raportowania,
- wytyczne dotyczące składania danych,
wytyczne administracyjne.
Ustandaryzowany proces opracowywania
Nowością jest także wdrożenie ujednoliconego procesu tworzenia wytycznych. Ma on zwiększyć ich przejrzystość, identyfikowalność oraz przewidywalność dla użytkowników.
Jak wskazuje EFSA, zmiany te mają usprawnić cały proces oceny ryzyka w obszarze bezpieczeństwa żywności oraz ułatwić przygotowanie dokumentacji przez wnioskodawców.
Dokumenty wytyczne EFSA stanowią podstawę dla prowadzenia ocen naukowych, projektowania badań oraz przygotowywania dokumentacji aplikacyjnej w UE. Ich większa dostępność i przejrzystość mogą przyczynić się do:
- skrócenia czasu przygotowania wniosków,
- zwiększenia spójności danych,
- poprawy efektywności oceny ryzyka,
- lepszej komunikacji między instytucjami i biznesem.
Wprowadzone zmiany wpisują się w szersze działania EFSA na rzecz cyfryzacji oraz zwiększania transparentności procesów naukowych w europejskim systemie bezpieczeństwa żywności.
Źródło: https://www.efsa.europa.eu/en/news/efsa-guidance-documents-new-catalogue-improve-access-and-use
Przeczytaj także
-
13.04.2026
13.04.2026
Podsumowanie i analiza danych z RASFF za rok 2025 – raport FoodFakty już dostępny!
Czytaj więcejJak kształtowały się notyfikacje w systemie RASFF w 2025 roku? Raport FoodFakty Risk podsumowujący powiadomienia o produktach niebezpiecznych zgłoszonych do RASFF w 2025 jest już dostępny.
-
 07.04.2026
07.04.2026
Nanoplastiki z opakowań mogą zwiększać wirulencję Salmonella – nowe implikacje dla bezpieczeństwa żywności i materiałów opakowaniowych
Czytaj więcejNanoplastiki powstające w wyniku degradacji tworzyw sztucznych mogą wpływać na zachowanie bakterii chorobotwórczych. Nowe badania wskazują, że kontakt z nanoplastikami polistyrenu może zwiększać zdolność Salmonella enterica do tworzenia biofilmów i zmieniać ekspresję genów wirulencji, co może mieć znaczenie dla bezpieczeństwa żywności i środowiska produkcyjnego w przemyśle spożywczym.
-
 01.04.2026
01.04.2026
KE opublikowała właśnie draft wytycznych i zestaw pytań i odpowiedzi dot. rozporządzenia PPWR
Czytaj więcejNa stronie KE pojawił się dokument z pytaniami i odpowiedziami, który w przystępny sposób wyjaśnia kluczowe założenia oraz obowiązki wynikające z nowych przepisów dotyczących opakowań i odpadów opakowaniowych.













.png)
.png)
